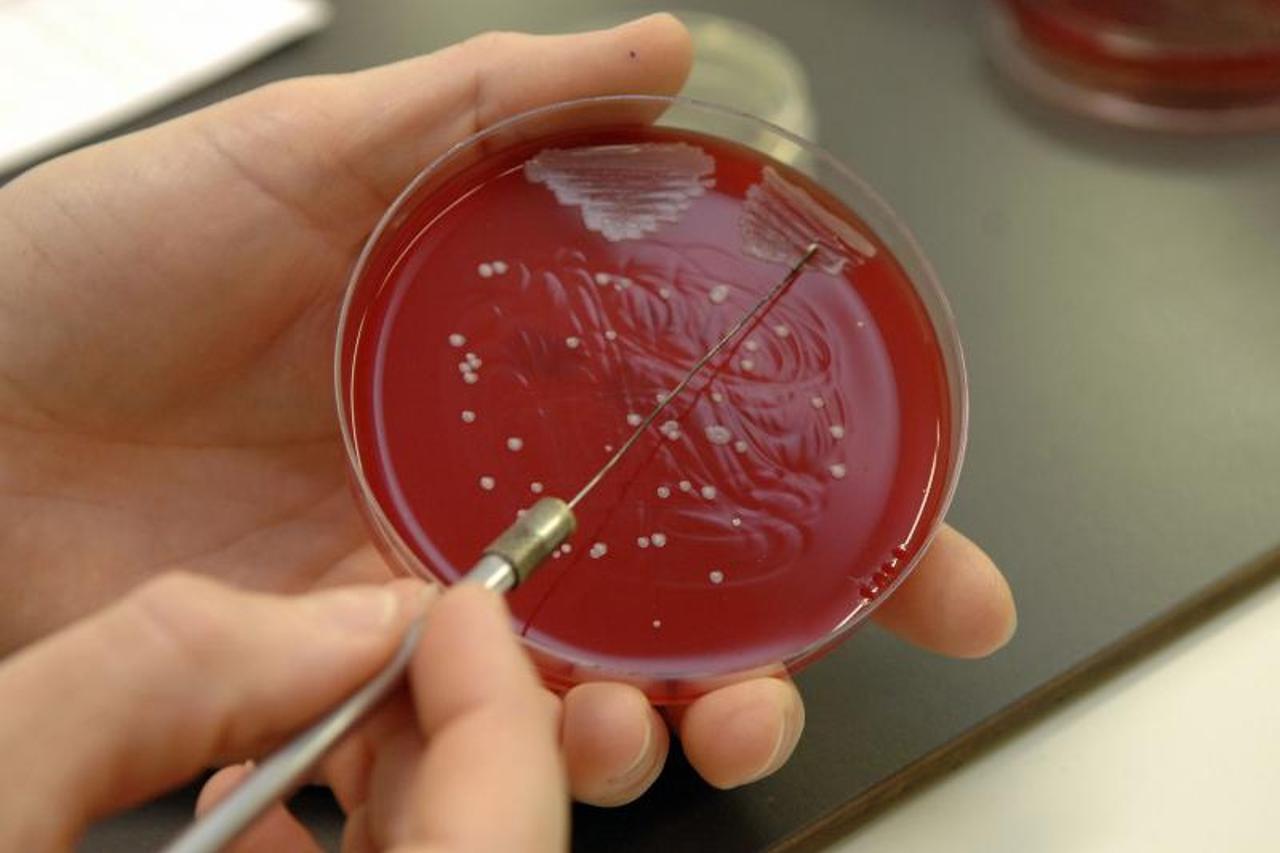
Antibiotik

2
LJUDSKO TIJELO KAO IZVOR LIJEKA
Borbom bakterija u nosu do novih antibiotika
Stručnjaci sa sveučilišta u Tübingenu u Njemačkoj smatraju da je ljudsko tijelo nepresušan izvor novih lijekova